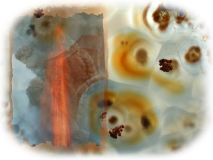

Beschreibung von Heilsteinen A
Achat
Farbe: verschieden
hilft für: Ruhe, Geborgenheit, geistige Reife, Menschenkenntnis, Phantasie, Magen, Darm, innere Organe, Gebärmutter, hilfreich und schützend bei Schwangerschaft
hilft gegen: Epilepsie
In der Antike wurde der Achat oft als Schutzamulett getragen. Ihm wurden auch glückbringende Wirkungen zugeschrieben, wobei sich die Bezeichnung auf „Glück“ meist auf das Seelenglück bezieht.
Der Achat gibt uns Geborgenheit und ein Gefühl von Behaglichkeit. Besonders Kinder finden in der Achatgeode Ruhe und Geborgenheit. Ziellose und unausgeglichene Menschen, läst der Achat wieder zu sich selbst finden, und die Hektik und Gefühllosigkeit die uns oft umgibt vergessen.Der Achat fördert das gefühlvolle, realistische und positive Denken, dadurch werden wir im geistigen Bereich reifer (überlegter) und wir können uns in der Vielzahl von Dingen die auf uns einströmen, besser zurechtfinden. In seinen vielfältigen Formen und Farben fördert der Achat die Phantasie, ebenso vermittelt er mehr Einfühlungsvermögen und lässt uns dadurch andere Menschen leichter verstehen.Im Bereich des Magens und des Darms, löst der Achat Blockaden und fördert die Regeneration der Verdauungsorgane. Vor allem den durch Stress und Aufregung gereizten Magen und Darm, beruhigt er wieder. Dabei sollte man einen Achat auf den Bauch legen, oder ihn in der Hosen- Rocktasche bei sich tragen.
Für schwangere Frauen ist der Achat und der dafür bekannte Aprikosenachat, ein sehr hilfreicher Stein, er lässt die Schwangerschaft mit ihren Problemen leichter überstehen und bietet Schutz für das ungeborene Leben. Der Achat hilft auch bei Gebärmuttererkrankungen und unterstützt die Zellregeneration.
Der weiße Achat, auch Friedensachat genannt, gibt durch seine reine weiße Farbe eine friedliche und beruhigende Energie, die den Kopf und Herzbereich von schweren Lasten befreit. Er bringt dadurch wieder ruhiges und klares Denken und erlöst uns von Beklemmungen, Hektik und Unruhe.
Achtung! Der Achat wird in vielen Fällen eingefärbt. Er kommt in der Natur nicht dunkelblau, grün, rot oder pink vor.

Achatgeode
Farbe: unterschiedlich, wird oft blau, grün, rot oder pink gefärbt.
hilft für: Die Achatgeode vermittelt insbesondere Kindern, Schwerkranken und behinderten Menschen, Geborgenheit und Schutz. Ihr Hohlraum ist meist mit Kristallen ausgekleidet und bietet ein Schauspiel der Natur, das kindlich ausgedrückt, mit einer Schatztruhe zu vergleichen ist. Von außen ist ein Achat oder eine Achatgeode unscheinbar, und gleicht in unseren Augen eher einem Kieselstein. Doch im Inneren des Steines verbergen sich die wahren Werte, welche die Menschen meist übersehen. Für Glücksgefühl, Ruhe, Harmonie usw.
Alexandrit
Farbe: grau, grünlich. Im Kunstlicht: rötlich bis violett, grau- violett.
hilft für: Für Nervensystem, Kreativität, Phantasie, Selbstwertgefühl. Der Alexandrit ist ein sehr teurer Stein, daher ist zu überlegen ob es nicht einen günstigeren Heilstein mit ähnlichen Eigenschaften gibt.
hilft gegen: geistige Probleme, Entzündungen.

hilft für: Ruhe, Ausgewogenheit, Entspannung.
Hilft gegen: Stress, Hektik, Unruhe, Verspannungen, Krämpfe, durch Stress und Aufregung verursachte Herzbeschwerden.
Der Amazonit vermittelt uns mit seiner schönen grünen Farbe, mehr Ruhe und Ausgewogenheit, damit befreit er uns von Stress, Hektik, Nervosität und hilft deshalb auch bei Herzbeschwerden die durch Stress oder Aufregung verursacht werden.
Im Alltag lässt uns der Amazonit lockerer werden, dabei verhindert er krampfhafte Bemühungen, die uns nicht weiter helfen. Er fördert somit die Geduld und bringt uns dabei schneller ans Ziel.
Der Amazonit wirkt durch seine entspannende und beruhigende Ausstrahlung auf den gesamten Körper, so lindert er Verkrampfungen und Muskelverspannungen.
Amethyst
hilft für: Ruhe, Schlaf, Meditation.
Hilft gegen: Stress, Nervosität, Angst, Wut, Kopfschmerzen- (Migräne), Ärger,
Unruhe, Krampfadern, Sucht, Schlafstörungen, seelische Belastung.
Der Amethyst ist einer der Heilsteine die in unserer Zeit am häufigsten benötigt werden, da viele Krankheiten und Beschwerden durch Unruhe, Nervosität, Stress, Hektik und Unausgeglichenheit verursacht werden. So macht uns der Amethyst ruhiger, gelöster und befreit uns von seelischen Belastungen und Ängsten. Ebenso fördert er das vertrauen an sich Selbst und hilft uns leichter vom Alltag abzuschalten.
Der Amethyst ist ein guter Helfer bei Kopfschmerzen und Schmerzen im allgemeinen. Bei Kopfschmerzen und Migräne empfiehlt es sich, mit einem Amethystkristall die schmerzende Stelle zu massieren. Bei Krampfadern ist es am geeignetsten den Stein direkt aufzulegen. Um Nervosität zu verneiden, sollte man einen Amethyst mit sich führen, oder als Anhänger tragen, bei starker Nervosität ist es ratsam einen Amethyst in die Hand zu nehmen, und dabei bewusst mit ihm zu arbeiten. Um Stress, Hektik und innerer Unruhe zu vermeiden (beseitigen) kann ebenso vorgegangen werden.
Gegen Magenschmerzen die von Stress, Ärger oder Nervosität herrühren, hilft der Amethyst auch sehr gut.
Bei Schlafstörungen die durch aufwachen und nicht mehr einschlafen (oft durch zu viele Gedanken im Kopf) verursacht werden, ist es ratsam einen Amethystkristall in die Hand zu nehmen oder unter das Kopfkissen zu legen. Sehr gute Wirkung erzielt man bei Kindern, indem der Amethyst mit dem Rosenquarz kombiniert wird.
Auch zur Meditation ist der Amethyst ein sehr hilfreicher Stein, da er das Geistige in unserem Körper (Kopf) aktiviert und es dadurch besser genutzt werden kann. Ebenso steigert der Amethyst die Wahrnehmung und lässt uns die Umwelt besser verstehen.
Bei starker Akne, Neurodermitis, und Hautallergie die durch Energieblockaden verursacht werden, kann man einen Amethyst (Amethystkristall) auf die betroffene Stelle auflegen, oder sie vorsichtig mit dem Amethystkristall massieren. Ansonsten ist der Aventurin bei Hautallergien, Akne usw. sehr hilfreich.
Offen aufgestellt oder offen getragen bietet der Amethyst auch einen gewissen „Schutz“ vor negativen Einflüssen. Um Sucht und suchtartige Auswirkungen, wie zum Beispiel das rauchen und übermässige trinken von Alkohol zu verringern (vermeiden) sollte man stets einen Amethyst bei sich führen und bei jedem Anreiz, den Stein in die Hand nehmen.
Der Amethyst eignet sich sehr gut, um andere Heilsteine wieder mit Energie zu versorgen (aufzuladen). Hierbei genügt ein ca. Handteller grosses Amethyststück mit vielen Kristallen, auf diesem Stück können genauso gut Medikamente oder Schmuckartikel mit positiver Energie versorgt werden. Die besten Voraussetzungen bietet eine Amethystdruse, ein Hohlraum der mit Amethystkristallen ausgekleidet ist. Auch um Räume positiv zu beeinflussen eignen sich Amethystdrusen oder grössere Amethyststücke hervorragend.
Ametrin
Farbe: violett und gelb bis bräunlich.
hilft für: Lebensfreude, Wohlbefinden, Harmonie, Nervensystem, Kreativität, Stoffwechsel.
hilft gegen: Gegen Stress, Nervosität, Depressionen.
Amulettstein
Australischer Amulettstein / Donnerei
Farbe: unterschiedlich (Achat- Art).
hilft für: Immunsystem, Leber, Verdauung, Stoffwechsel, Haut, Harmonie, unterstützt Heilungsprozesse, dient bei den Ureinwohnern Australiens "Aborigines" als Schutzamulett.
hilft gegen: Wetterfühligkeit, Zorn, Wut, Unausgeglichenheit.
Der Amulettstein dient den Ureinwohnern Australiens, „Aborigines“ als Schutzamulett.
Andenopal grau
Farbe: grau
hilft für: Herz, Nervensystem.
hilft gegen: Depressionen.
Andenopal grün
Farbe: grün
hilft für: Herz, Erholung, Nerven, Nieren, Entgiftung.
hilft gegen: Ängste.



Andenopal rosa
Farbe: rosa
hilft für: Herz, Freundlichkeit.
hilft gegen: Sorgen, Hemmungen.
Anhydrit
Farbe: grau, hellblau bis intensiv himmelblau.
hilft für: Ruhe, Entspannung, Geduld, Bewusstsein.
hilft gegen: seelische Belastung, Stress, Unsicherheit.
Antimonit / Grauspießglanz
Farbe: grau bis schwarzgrau.
hilft für: geistige Ausgewogenheit, Neuanfang, Erdung.
hilft gegen: Ausschläge, Ekzeme.
Apachenträne
Farbe: schwärzlich dunkelbraun, im Licht durchscheinend.
hilft für: Energie, Kraft, Ausdauer, bessere Wahrnehmung, Verdauung.
hilft gegen: Angst, Depressionen, negative Gedanken.
Die Apachenträne wirkt im feinen Bereich der Energien fast bei jedem Menschen etwas anders. Die Apachenträne hat auch ein kleines Geheimnis. Wenn sie auf dem Tisch liegt, sieht sie unscheinbar und schwarz aus, aber gegen eine Lichtquelle gehalten ist sie durchscheinend und rauchbraun. Eine besondere Wirkung kann man erzielen in dem eine Apachenträne mit einem Milchquarz- Trommelstein gemeinsam angewendet wird. Dabei erhält man eine Art Jing- Jang- Energie (Ausgleich, Ausgewogenheit), die Frieden und Treue in eine Partnerschaft (Familie) bringt.
Apatit
Farbe: blau etwas grünlich, auch gelb.
hilft für: Ausgleich, Aktivität, Verdauung, Stoffwechsel, reinigende Energie, (Appetit).
hilft gegen: Stress, Ärger, Kummer, Lustlosigkeit.
Apophyllit
Farbe: meist farblos (klar), grünlich oder bläulich.
hilft für: Atemwege, Zuversicht, Gelassenheit, Ehrlichkeit.
hilft gegen: Ängste, Sorgen, Asthma, Beklemmungen.
Aprikosenachat
Farbe: grau- rosa, hellorange.
hilft für: Ruhe, Ausgleich, Harmonie, Besonnenheit, Magen, Darm, Gebärmutter.
hilft gegen: starke Stimmungsschwankungen (Depressionen).
Hilfreich und schützend bei Schwangerschaft.
Aquamarin
hilft für: Atemwege, Schleimhaut, Mandeln, Halsbereich, Lymphdrüsen, Gelassenheit.
Hilft gegen: Depressionen, Wetterfühligkeit, Wasseransammlungen.
Der Aquamarin bringt uns durch seine blaugrüne bis himmelblaue Farbe, Ruhe, Harmonie und Ausgewogenheit, die uns oft bei trübem Wetter oder Niedergeschlagenheit fehlt, so hilft er auch Gelassener zu sein und lindert damit Depressionen.
Er reinigt unsere Atemwege und hilft bei Asthma, die verengten Atemwege zu öffnen. Bei Mandelentzündung bekämpft der Aquamarin die krankheits- verursachenden Bakterien.
Der Aquamarin harmonisiert den Hormonhaushalt über die Schilddrüse und Lymphdrüsen. Er verhindert auch ungewollte Wasseransammlungen im Körper.
Der Aquamarin hat eine kühlende Wirkung und hilft deshalb auch bei brennenden und überanstrengten Augen, ebenso wie der Smaragd und der Beryll. Am besten legt man dabei den Stein für ein paar Minuten auf die geschlossenen Augen.
Achtung! Der Aquamarin wird oft gebrannt oder bestrahlt um eine schönere Farbe zu erzielen. Mitunter wird der Aquamarin , meist als Schmuckstein in Ringen und Anhängern gefasst, synthetisch hergestellt.
Aragonit / Eisenblüte
Farbe: braun, rotbraun, grau bis weiß (Eisenblüte)
hilft für: Wachstum, Knochen. (Die Aragonit - Eisenblüte sorgt ausserdem für klare Harmonie und Gedanken)
hilft gegen: körperliche Empfindlichkeit, Muskelbeschwerden, Zittern.
Atakamit
Farbe: intensives grün.
hilft für: Kreativität, Vitalität, innere Kraft und Ausgewogenheit, Nervensystem.
hilft gegen: seelische Belastung, Unausgeglichenheit.




Aventurin
hilft für: Ruhe, Ausgleich, Entspannung, Schlaf, Heiterkeit, Herz, Bindegewebe.
Hilft gegen: Hautallergien, Ekzeme, Neurodermitis, Ausschläge, Ärger.
Der Aventurin bringt Ruhe und Ausgewogenheit in unser Nervensystem, da seine grüne Farbe beruhigend und entspannend auf den gesamten Körper wirkt. Dadurch lindert er auch Herzbeschwerden die durch Aufregung oder Stress entstehen. Ebenso wirkt er beruhigend vor dem Einschlafen.
Hilfreich ist er bei Hautallergien und Neurodermitis. Dabei empfiehlt es sich den Stein auf der Haut zu tragen oder auf die erkrankte Stelle zu legen. In manchen Fällen kann es im Anfangsstadium zu einer kurzzeitigen Verschlechterung der Allergie kommen, wird aber dann von einer „Heilfase“ abgelöst.
Der Aventurin trägt auch zur Heiterkeit bei, da er die Menschen gelöster und freier vom Alltagsstress macht.
Azurit
hilft für: Konzentration, bessere Wahrnehmung, Verstand, Bewusstsein, Meditation, drittes Auge, geistige Aufnahmefähigkeit, Nervensystem, fördert die Hellsichtigkeit.
Hilft gegen: Prüfungsangst.
Der Azurit ist ein Stein der uns mehr von unserer Umwelt vermittelt, in dem er uns hellsichtig und hellhörig macht. Dadurch stärkt er unsere Wahrnehmung im geistigen Bereich. Der Azurit erhöht somit auch die Konzentration, die Tätigkeit des Gehirns und der Nerven.
Viele Kinder, Jugendliche und Erwachsene haben vor einem Test (Prüfung) die Antworten parat, doch wenn es zur Prüfung kommt ist plötzlich alles wie weggeblasen. Hier hilft der Azurit, die Angst zu vergessen und sich auf den bevorstehenden Test zu konzentrieren.
In diesem Fall empfiehlt es sich einen Azurit in der Hosentasche mit sich zu führen, oder als Anhänger zu tragen.
Beim meditieren oder zur geistigen Regeneration kann man einen Azurit in die Hand nehmen, dabei wird die mentale Aufnahmefähigkeit gesteigert .
Der Azurit lässt uns bewusst werden, was für geistige Kräfte in uns stecken. Er fördert die Entscheidungskraft und den Tatendrang und dadurch sorgt er auch, dass etwas das schon längere Zeit gemacht werden sollte (geplant war), zu Ende zu bringen.

